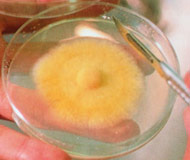
メシマコブ菌糸体「PL2」「PL5」

会員登録すると、さらにお安く
ご購入いただけます。
●代引き・振込手数料無料。(銀行振込・郵便局現金払いは除く)
メシマピュア PL2・PL5(30包)
会員登録すると、さらにお安く
ご購入いただけます。
●代引き・振込手数料無料。(銀行振込・郵便局現金払いは除く)
メシマコブ菌糸体 PL2とPL5(特許取得)使用!
「メシマピュア(メシマコブ菌糸体)」は、メシマコブの中でも最も優れており変異しにくいと云われるPL2とPL5(特許 第3093194号)を厳選し、PL2とPL5菌糸体のみを熱水抽出し製品化しています。
メシマピュアは、その原料(メシマPL2とPL5)を、日本の厳しい生産管理のもとでそのまま顆粒状にしました。
(株)韓国新薬の原料(メシマPL2・PL5)を100%使用しています。
■1袋(1.1g)中 α-D-グルカン 0.11g
『メシマピュア』は、メシマ普及協議会認定の特許を取得しています。
特許番号 第3093194号
| 名称 | メシマコブ熱水抽出物加工食品 |
|---|---|
| 原材料名 | メシマコブ熱水抽出物(韓国製造)、乳糖、デキストリン |
| 内容量 | 33g(1.1g×30袋) |
| 保存方法 | 直射日光・高温多湿を避けて保存してください。 |
| 栄養成分表示 ※1袋(1.1g) あたり |
|
| 召し上がり方 | 1日1袋~3袋を目安に、水またはお湯などと一緒にお召し上がりください。 |
ご注意
◆体質や体調によって合わないこともございます。その際はご使用を中止してください。
◆妊産婦および薬剤を処方されている方は、医師・薬剤師にご相談ください。
メシマコブとは?

メシマコブは、タバコウロコタケ科のキノコです。
長崎県男女群島の女島(めしま)で発見され、桑の木にコブ状に自生することからこの名がつきました。
キノコ類の主成分である多糖体の中でもβ-グルカンに有用成分が多く含まれていると考えられており、中国では、古くから漢方薬として利用されています。
このメシマコブの食効については、30年以上前から国内外の機関で研究を重ねてきましたが、このメシマコブの製品化は大変難しく、幻のキノコといわれてきました。
メシマコブ菌糸体「PL2」「PL5」とは?
韓国新薬製の原料メシマ®PL2・PL5は、韓国国家プロジェクトにより菌糸体培養に成功したメシマコブ菌糸体抽出物です。
メシマコブ菌糸体の中でも活性が高く、遺伝変異の少ない菌株がPL2・PL5という菌株です。
日本・韓国などからメシマコブ菌株13種類を集め、その結果として、最も変異のない菌株PL2・PL5菌糸体を熱水抽出したエキスを使用した製品を開発しました。
メシマ®の関与成分はポリサッカライド(polysaccharide)と呼ばれる多糖類です。
αグルカン、βグルカンなどの多糖類のほか、マンノース、ガラクトースなどの複数の単糖で構成されていることが特徴です。特に酸性ヘテロマンナンタンパク複合体が特徴的な成分です。
またメシマ®の分子量は約15万で、他のキノコ類と比べて分子量が大きいことも特徴の1つです。メシマ®は特定の成分や分子量の大きさによるものではなく、複数の成分の働きによって寄与しています。
メシマの安全性について
原料元である韓国新薬での安全性試験(GMP(基準)での、変異原性、毒性試験)および製品の規格確認を行っており、確認項目は以下の通りです。
■復帰突然変異試験:陰性(-)
■急性経口毒性試験:LD50/RAT、2g/kg以上、有意な毒性徴候なし
■亜急性(反復)経口毒性試験:4週間投与/RAT、無毒性量は1g/kg/day以上
■原料品質:重金属、砒素、大腸菌等検査問題なし



